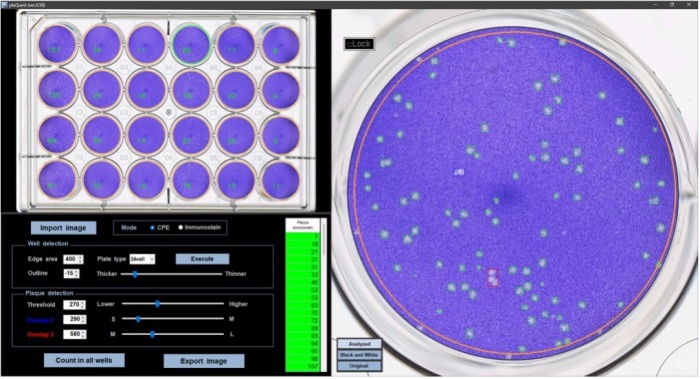

大阪医科薬科大学
大阪医科薬科大学 医学部 生物安全実験研究室(鈴木陽一特務教授)と微生物学・感染制御学教室(中野隆史教授)の研究グループは、病原ウイルスの感染力を効率よく定量できる新しい自動解析ソフトウェア「plaQuest(プラークエスト)」を開発しました。従来、研究者が目視で数えていたウイルスプラークを自動で高精度にカウントできることが示され、薬剤の開発研究などで必要となるウイルス定量作業の大幅な効率化が期待されます。
研究のポイント
- ウイルス感染によって培養細胞に作られるプラークを自動的にカウントするソフトウェア「plaQuest」を開発。
- 研究者が目視でカウントしたプラークの数とplaQuestが自動カウントしたプラーク数には高い相関がみられた。
- プラークの形成はウイルスの感染力の指標となることから、plaQuestはウイルス阻害薬の開発研究での活用が期待できる。
研究の概要
ヒトに病気を起こすウイルスの多くは、増殖するために細胞に感染すると、その感染細胞を殺してしまいます。これはウイルスの細胞変性効果と呼ばれ、感染力のあるウイルスの存在を知る指標となります。
ウイルスの細胞変性効果によって死んだ細胞の集団をプラーク(Plaque)と呼びますが、プラークが目視で確認できる大きさになると、プラークの数を数えることでウイルスの感染力(感染価)を数値化することが可能となります (図1)。


これは、薬剤試験などの多量のサンプルを一度に扱うような実験では、特に大変な労力を要し
ます。
本研究では、細胞培養プレートに作られたウイルスのプラークを自動的にカウントするソフトウェア 「plaQuest」 を開発し (図3)、ウイルス阻害剤の評価試験における有用性を検証しました。

したがって、plaQuestは、抗ウイルス薬の開発を目的とした研究に大変有用なツールであることが示され、その活用が期待されます。
研究の背景
新型コロナウイルス感染症の流行時には、ウイルス感染の有無をみるためにPCR検査や抗原検査が幅広く使われました。しかし、これらの検査手法は、基本的に化学物質としてのウイルス(核酸やタンパク質)を検出するものであり、微生物として活動状態にある(つまり感染力のある)ウイルスがどれだけいるのかを判断するものではありません。一方、ウイルスの感染力を調べる方法として、プラークアッセイ法があります。プラークアッセイ法は、ウイルスがもつ細胞を殺す力(細胞
変性効果)を利用して、死んだ細胞の集団(プラーク)を可視化し、プラークの数を使って感染力を数値化する手法です。数値化された感染力を感染価と呼びますが、プラークアッセイ法はウイルス学研究における感染価の測定方法として標準的に使われてきました。しかし、プラークアッセイ法の難点は、細胞培養プレートに無数に現れた小さなプラークを目視でカウントしないといけないことでした。そのため、例えば様々な種類の薬剤のウイルス阻害効果を検定しないといけないような実験では、プラークのカウントは大変な労力を必要とする作業でした。また、作業者によってプラークの識別方法やカウント方法に違いがあり、それが数値結果に影響することもあります。こういった作業負担の軽減や結果の均一性を目的として、本研究では、ウイルスプラークを自動的に識別しカウントするソフトウェア 「plaQuest」 の開発に至りました。
社会的影響
プラークアッセイ法は、感染力をもつウイルス量を直接数値化できることから、ウイルスの増殖動態を調べるうえで極めて有効であり、病原ウイルスに対する薬剤やワクチンの開発には欠かせない技術です。本研究で開発した自動プラークカウントソフトウェア plaQuest を組み合わせることで、これらの研究プロセスを効率的に進められるだけでなく、解析技術の標準化や再現性の向上にもつながります。
こうした有用性により、plaQuest はウイルス感染症の治療や予防に関する研究を着実に前進させることが期待されます。
用語説明
細胞変性効果
ウイルスは、細胞に寄生(感染)することでしか増殖できないが、その際、宿主となる細胞に様々な変化を引き起こし、これを総称して細胞変性効果と呼ぶ。細胞変性効果には、細胞死の誘導だけでなく、細胞同士の融合や細胞の不死化なども含まれる。
プラークアッセイ法
感染力をもつウイルスの量を測定する生物学的方法である。ウイルスに感受性の細胞を培養用プレートに密に播種し、適度に希釈したウイルス液と培養すると、ウイルスの細胞変性効果によって感染した細胞、そしてその周辺の細胞が数日で死滅する。死滅した細胞の集団は、培養プレートから剥離するため、クリスタルバイオレットなどの染色液で細胞を染色すると、細胞変性効果によって細胞が剥離した領域は染まらず色が抜けたように見える。この色が抜けた部分を「プラーク」と呼ぶ。プラークは感染能力(感染性)のあるウイルスが作り出したものと考えられるため、培養プレートにどれだけの感染性ウイルスが加えられたのかを最終的に目視で知ることができる。
チクングニアウイルス
ヤブ蚊によって媒介されヒトに発熱性疾患(チクングニア熱)を引き起こす熱帯性ウイルスである。我が国における国内感染症例はこれまでに確認されていないが、ウイルスを媒介する蚊は日本にも生息することから国内での流行が絶えず懸念されている。
新型コロナウイルス
2019年末に中国で最初の感染例が報告され、その後、世界的な大流行となったCOVID-19の原因ウイルスである。このウイルスの特徴としては、培養細胞に対する強い細胞変性効果が挙げられる。
デングウイルス
チクングニアウイルスと同様にヤブ蚊によって媒介され、デング熱を引き起こす熱帯性のウイルスである。我が国では、海外で感染した人が国内で発症する場合が多いが、2014年の夏には東京を中心とする国内流行が発生した。
特記事項
本研究内容は、2025年4月に Scientific Reports 誌に掲載されました。“Development of an automated plaque-counting program for the quantification of the Chikungunya virus.”
著者:Akino Emi, Youichi Suzuki, Chinami Odake, Shoichi Sakaguchi, Hong Wu, Takashi Nakano
DOI:10.1038/s41598-025-97590-3
本研究結果は、日本医療研究開発機構(AMED)の課題番号JP24fk0108656の支援を受けて行われました。
また、「plaQuest」は、下記の研究においてもウイルスプラークの定量解析に活用されました。
Structure-guided engineering of a mutation-tolerant inhibitor peptide against variable SARS-CoV-2 spikes
著者:Shun Nakamura, Yukihiro Tanimura, Risa Nomura, Hiroshi Suzuki, Kouki Nishikawa, Akiko Kamegawa, Nobutaka Numoto, Atsushi Tanaka, Shigeru Kawabata, Shoichi Sakaguchi, Akino Emi, Youichi Suzuki, Yoshinori Fujiyoshi
掲載誌:PNAS, Vol. 122, Issue 4, Article e2413465122 (2025)
DOI: 10.1073/pnas.2413465122 [pnas.org]
本件に関するお問い合わせ
● 本研究について
大阪医科薬科大学 医学部
生物安全実験研究室
特別職務担当教員(教授)
鈴木 陽一(すずき よういち)
youichi.suzuki@ompu.ac.jp
● リリースについて
大阪医科薬科大学
総務部 企画・広報課
hojin-koho@ompu.ac.jp
072-684-6817(直通)
